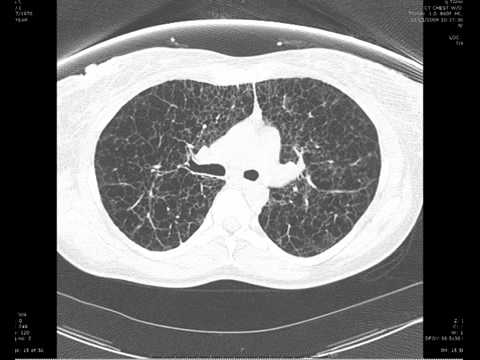

マイストア
変更
お店で受け取る
(送料無料)
配送する
納期目安:
2025.10.05 21:33頃のお届け予定です。
決済方法が、クレジット、代金引換の場合に限ります。その他の決済方法の場合はこちらをご確認ください。
※土・日・祝日の注文の場合や在庫状況によって、商品のお届けにお時間をいただく場合がございます。
High-Resolution CT of the Lung 第5版 High-Resolution CT of the Lungs | AJRの詳細情報
High-Resolution CT of the Lungs | AJR。High resolution CT scan of the chest showing the lung。41598_2021_94702_Fig3_HTML.png。肺の高解像度CTに関する詳細な情報を提供する専門書。- タイトル: 肺HRCT 原書第5版- 著者: W. Richard Webb, Nestor L. Müller, David P. Naidich- 出版社: Wolters Kluwer- ページ数: 厚みありご覧いただきありがとうございます。。Axial CT images of the lung (5mm slice thickness) before and。治癒の歯内療法 新版
ベストセラーランキングです
近くの売り場の商品
カスタマーレビュー
オススメ度 4.1点
現在、2481件のレビューが投稿されています。